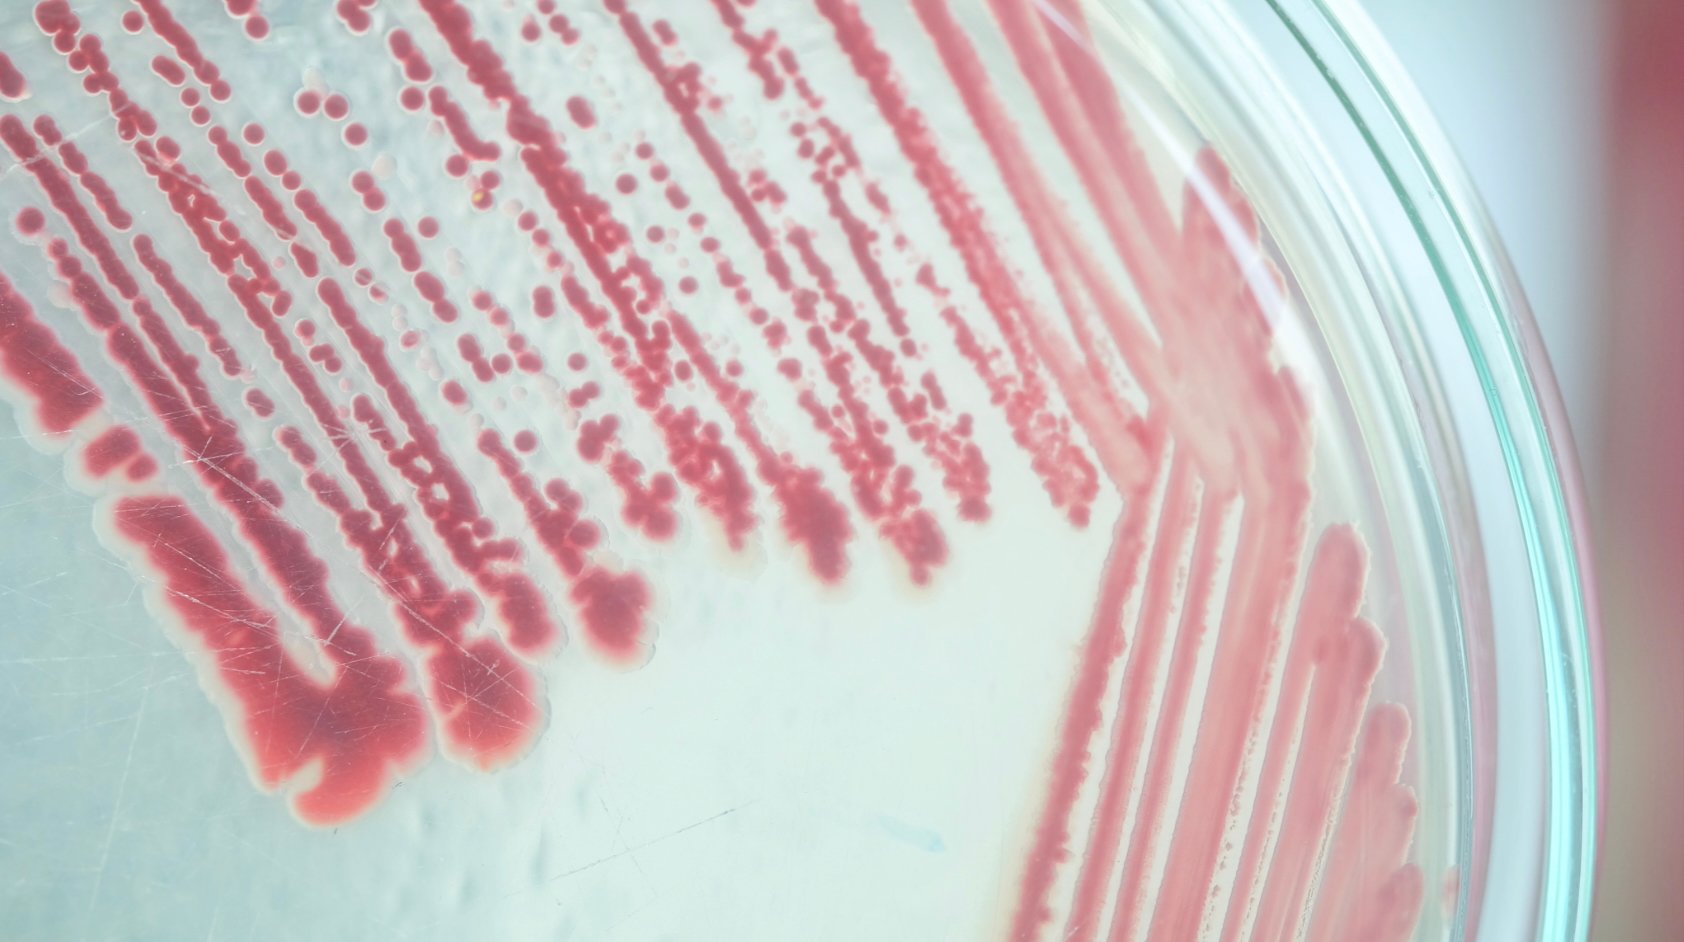
Pink mould, which is really a bacteria, growing on a petri dish.

February 8, 2026

View Posts By Topics
- Hot Tubs (49)
- Swim Spas (35)
- Maintenance (24)
- purchase advice (17)
- Hydrotherapy (16)
- Fitness (13)
- Water Chemistry (11)
- BBQ Cabins (10)
- Garden Design (10)
- Troubleshooting (10)
- Tips & Tricks (9)
- Garden Buildings (6)
- Hospitality (6)
- Hydropool Exclusive (5)
- Recipes (4)
- Science (4)
- Party Planning (3)
There is nothing quite like stepping into your Hydropool hot tub after a long day in the office or a chilly afternoon walking the dogs around the Peak District. That crystal-clear, inviting water is the hallmark of a luxury spa experience. However, if you have ever lifted your cover to find a strange, rose-coloured film along the waterline or tucked into the jets, you have met a common but unwelcome guest: pink mould.
While the name sounds like something out of a science fiction novel, it is a reality that many hot tub owners face at some point, and may be familiar with already from its more common bathroom home. Let’s dive into what it is, why it appears, and how to ensure your Manchester garden remains a sanctuary of cleanliness.
What Exactly Is Pink Mould?
Despite its common name, "pink mould" is actually a type of bacteria known as serratia marcescens. It is often confused as pink algae in hot tubs, but unlike real algae or mould even, this bacteria thrives in moist, dark environments and feeds on sloughed-off skin cells, soaps, and lotions. It is commonly seen in bathrooms, around the silicon caulking or grout lines near the shower or bath. Usually diluted vinegar or bleach is what you would use to clean it in the bathroom.
It usually presents as a slimy, pinkish or orange-hued film. While it is not a major health crisis for most healthy adults, it is a sign that the "ecosystem" of your hot tub is out of balance. If left unchecked, it can lead to respiratory irritation or skin issues, and it certainly takes the "luxury" out of your soak.

Why Does It Happen In My Luxury Spa?
Seeing a pink ring around your hot tub can be a bit disheartening, especially when you have invested in a premium Hydropool. If you spot it, it is usually a signal that one of your spa’s defense systems needs a little TLC:
-
The Ozonator Needs a Check: Your Hydropool is equipped with an ozonator that helps kill bacteria. If the unit is reaching the end of its lifespan (usually 2–3 years), its ability to oxidise organic matter drops, giving bacteria a foothold.
- Filter Saturation: Our self-cleaning technology is industry-leading, but even the best filters need regular rinsing. If the filter is clogged with oils or biofilm, the water flow decreases, and the bacteria find a place to hide. You should clean your filter with water once a week, use filter cleaner spray every two weeks or so depending on your hot tub use, and soak your filter with filter cleaner once a month.
- Biofilm Buildup: Sometimes, bacteria can hunker down inside the internal pipework. This "biofilm" acts like a protective suit for the mould, shielding it from the chlorine or bromine in the water. You should use a hot tub flush every few months to get rid of that build up, empty and refill your tub afterwards.
Pink Mould Vs. Pink Algae Vs. Pink Bacteria
Here is why the distinction between algae, mould, and bacteria matters for your hot tub care:
Real algae (like the green or mustard varieties) use photosynthesis to grow. This is why you’ll often see green algae thrive in spas that get a lot of Manchester sunshine. Pink "algae", however, is actually a form of bacteria that behaves more like a fungus. It isn’t an algae at all. It doesn't need light to survive; it just needs moisture and "food" like soap residue, lotions, or skin cells. This distinction is important, as algae and bacteria have two different ways to eradicate it.
Why Pink Mould Loves Hot Tubs
Even though it isn't a true algae, people call it that because it looks and feels similar—slimy to the touch and stubborn to remove. It is particularly fond of:
PVC Surfaces: It has a natural affinity for plastic, which is why you’ll often find it on the jets, the skimmer basket, or even the underside of your cover.
Nooks and Crannies: Because it doesn't need light, it loves to hide in the internal pipework, which can then grow layers of protective biofilm preventing sanitiser from reaching it.
How To Remove Pink Mould From Hot Tubs
The reason it’s important to know it’s a bacteria is that algaecides won't kill it. If you treat pink mould with a product designed for green algae, you’ll likely see it grow right back. To get rid of it, you need to use a high-dose "shock" treatment (oxidisation) and a deep clean of your filtration system to physically remove the colonies.
So, while the terms “pink algae” and “pink mould” are used by almost everyone in the hot tub world, just remember that you're actually dealing with a bacterial film that requires a deep clean approach rather than just a splash of algaecide. Read more about prevention and treatment below.
Prevention As Hot Tub Maintenance
Keeping your water pristine in the North West climate, where humidity and rain are our constant companions, requires a proactive approach. Proper hot tub maintenance is the secret to a lifetime of stress-free soaking.
Balance is Key: Regularly test your water. If your sanitiser levels (chlorine or bromine) dip too low for even a day or two, pink mould can seize the opportunity to grow.
The Deep Clean: Every 3–4 months, we recommend a full drain and refill. Use a specialized "pipe flush" before draining to clear out any hidden colonies inside the plumbing.
Filter Care: Rinse your filters weekly and soak them in a professional filter cleaner once a month. This ensures your self-cleaning system is operating at 100% efficiency.
Shower Before You Soak: Encouraging guests to rinse off perfumes, lotions, and self tanner prevents the "food source" for pink mould from entering the water in the first place.
To Eradicate Pink Mould From Hot Tub Water
-
Check your tub over. Make sure it is completely in working order with a service technician (optional).
- Deep clean the hot tub filter, or replace it entirely.
- Flush your hot tub, let the hot tub flush run though the tub for at least 20 minutes with all jets on high power.
- Empty and clean all surfaces extremely well.
- Refill your tub!
- Continue with preventative maintenance.
A Note On Quality
It is worth noting that pink mould in hot tubs is significantly more common in "lesser-tier" spas, such as inflatable tubs or budget-friendly models. These tubs often lack the powerful filtration and PureWater ozone/oxygen systems found in a Hydropool.
Furthermore, tubs that aren't kept at a consistent temperature are at higher risk. When water is allowed to cool down and sit stagnant, it becomes a breeding ground for bacteria. Because your Hydropool is designed to be energy-efficient and stay hot 24/7, the constant heat and circulation are your best natural defenses against growth.

At Hydropool North West, we pride ourselves on our aftercare. If you are struggling to get your water chemistry just right, or if you think your ozonator might need a service, our team is just a phone call away. We stock all the premium chemicals and accessories you need to keep your sanctuary spotless at our showroom. Get back to relaxing with a Hydropool Self-Cleaning hot tub.
Recent Posts

At Hydropool North West, we know that choosing a hot tub for your family is about more than just...

If you’ve spent the last couple of years enjoying a Lay-Z-Spa or a standard blow up hot tub, you...

If you have been browsing the market for a new addition to your garden in Greater Manchester,...

As the years roll by, we all start to value the quieter moments a little more. In the North West,...



